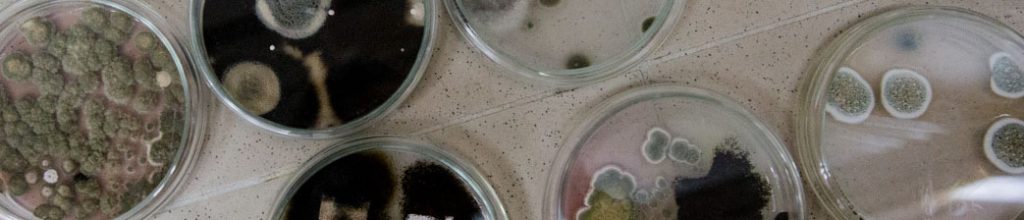
mould-testing-ireland

What we do
We get rid of mould contamination from surfaces.
- We decontaminate, clean and sanitize mould affected surfaces.
- We remove and dispose of unrecoverable mould damaged items safely.
- We repair mould damaged surfaces in most instances.
- We apply preventative anti-mould coatings to prone surfaces.
- We help you work to prevent and mitigate the recurrence of mould contamination.
Where we do it
- Hospitals, clinical and high-risk rooms and wards.
- Shopping centres, malls.
- Government buildings.
- Convention centres and similar public entertainment facilities.
- Buildings, residential, corporate and commercial.
- Homes, rentals.
- Anywhere mould needs to be remediated.
Why
Mould is unpleasant, unsightly and often emitting bad odours however, and most importantly, it is toxic and a danger to your health. Mould is not just a danger on the surfaces you may find it but an airborne contaminate as well. The spores that mould produce eventually settle and begins to consumes the moist surface it will thrive on. Mould will then release more spores potentially exacerbating skin and eye irritations, and more commonly breathing difficulties and respiratory problems and even headaches. Mould is an airborne heath risk that also damages the surfaces it lives off.